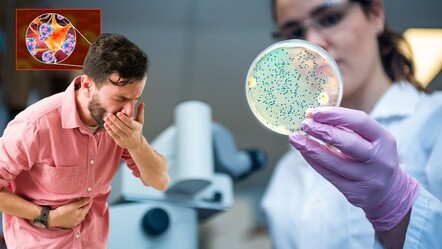

100 binde 1 görülüyor! 2 yıldır yemek yiyemiyordu, bir saatlik operasyonla sağlığına kavuştu

Kahramanmaraş'ta nadir görülen ve yutma güçlüğü olarak bilinen "akalazya" hastalığı nedeniyle 2 yıldır yeme ve içme problemi yaşayan 53 yaşındaki Hasan Karakök, uygulanan tedaviyle sağlığına kavuştu. Mutluluğunu paylaşan Karakök, “Su boğazımdan geçmiyordu. Yoğurt ve çorbalarla besleniyordum. Ameliyatımın ikinci gününde su içmeye başladım” dedi.
İstanbul'da yaşayan Hasan Karakök, yaklaşık 2 yıl önce mide bulantısı, kusma ve şiddetli sırt ağrısı şikayetiyle birçok hastaneye başvurdu ancak sonuç alamadı. Çeşitli tedavi yöntemleri denenen ama şikayetleri süren hasta, internetten yaptığı araştırma sonucu Kahramanmaraş’taki hastaneye başvurdu.
DÜNYADA 100 BİNDE BİR GÖRÜLÜYOR
Tahlil ve tetkikleri yapılan hastaya, yemek borusunun alt ucundaki kasın gevşememesi nedeniyle yutma güçlüğüne sebep olan akalazya hastalığı tanısı konuldu.
Dünyada 100 binde bir görülen hastalık yüzünden yeme içme güçlüğü çeken Karakök, yapılan tedavinin ardından sağlığına kavuşarak, 2 yıl sonra rahat bir şekilde yiyecek ve içecek tüketmeye başladı.
Hasan Karakök, hastalığından dolayı 2 yıldır yeme ve içme problemi yaşadığını, hatta uyuyamadığını söyledi.
Şikayetlerinden kurtulmak için uzun süre araştırma yaptığını anlatan Karakök, Kahramanmaraş’taki hastaneye başvurdu.

“SU BOĞAZIMDAN GEÇMİYORDU”
Ameliyatın ertesi günü rahatlıkla su içebilmenin sevincini yaşadığını ifade eden Karakök, şöyle konuştu:
"Hastalığımın tedavisi için araştırma yapıyordum ve ameliyat olan hastaların şifa bulduğunu gördüm. Dünyanın her yerinden insanlar tedavi için buraya geliyor. Kahramanmaraş 1 yıl önce büyük bir deprem yaşadı. Depremzede olmalarına rağmen hemşiresinden doktoruna kadar herkesin özveriyle çalışmaya devam ettiğine şahit oldum. Su boğazımdan geçmiyordu. Yoğurt ve çorbalarla besleniyordum. Ameliyatımın ikinci gününde su içmeye başladım. Doktorumuza ve ekibine teşekkür ediyorum."
Karakök, ameliyatının ardından rahatlıkla katı yiyecekler de tüketebildiğini dile getirdi.
BAŞARI ORANI NEREDEYSE YÜZDE 100
Ameliyatı gerçekleştiren Gastroenterolojik Cerrahi Uzmanı Doç. Dr. Bahtiyar Muhammedoğlu da akalazya hastalığının tedavisinin nadir sağlık merkezlerinde gerçekleştirildiğine işaret etti.
Tedavi için son teknolojiyi başarıyla kullandıklarını vurgulayan Muhammedoğlu, yurt içi ve dışından çok sayıda hasta kabul ettiklerini, başarı oranlarının neredeyse yüzde 100 olduğunu kaydetti.
POEM'in dünya genelinde akalazyanın en güncel tedavi yöntemi olduğuna dikkati çeken Muhammedoğlu, şöyle devam etti:
"Endoskopiyle yemek borusuna giriliyor, orada üstteki katmanı koruyarak bir tünel açılıyor. Darlığa sebep olan kaslar kesiliyor ve hastanın yaşadığı sıkıntı tamamen geçmiş oluyor. Operasyon genellikle 1 veya 1,5 saat sürüyor. Bu hastalıkla yaşayan hastalar için mesafe değil, sağlık önemli. Bu özellikli ameliyatlar hastanemizde dünya standartlarıyla rekabet edecek şekilde yapılıyor. Son yıllarda 2 binden fazla hastamızı laparoskopik cerrahi yöntemiyle sağlığına kavuşturduk. Özellikle endoskopik tedavi yöntemiyle 150'ye yakın akalazya hastasına POEM işlemi yaptık. Her hafta 2-3 akalazya hastasını tedavi etmekteyiz ki dünyada en büyük merkezlerde bile bu kadar rakam yok. Depremden sonra devletimizin kentimize, hastanemize sağladığı imkanları kullanarak hastalarımıza üst düzey hizmet veriyoruz."